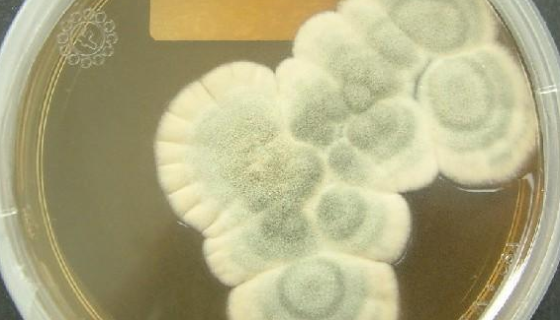
桔青霉的保藏条件与注意事项及打管说明！
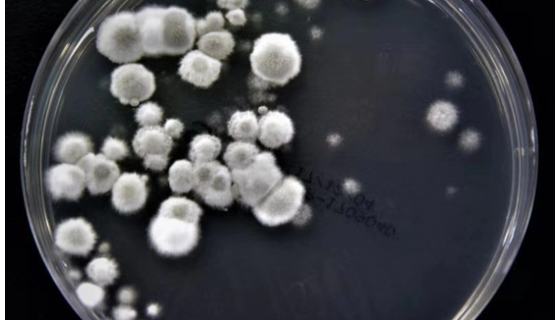
刺糖多孢菌的培养条件与保存方法及注意事项！
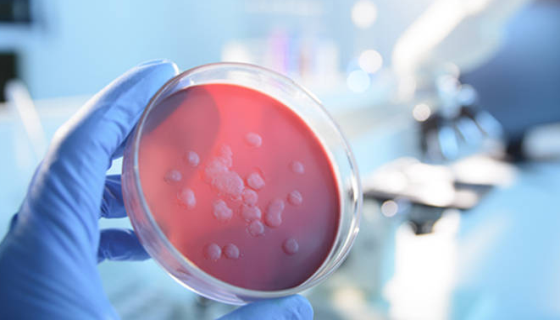
微生物检测过程中的常见问题及解答！
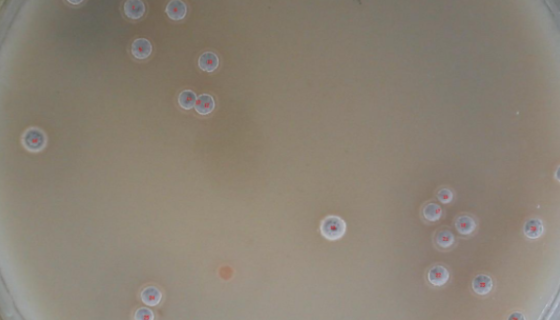
洋葱假单胞菌的生物学性状与细菌学检验方法！

桔青霉的保藏条件与注意事项及打管说明!
桔青霉是一种杯霉科真菌,本种的分生抱子面通常呈现典型的蓝绿色...

细胞迁移的背景与应用及实验方法!
细胞迁移指即细胞划痕法,是测定细胞迁移运动与修复能力的方法,...

大鼠Ⅱ型肺泡上皮细胞的背景与应用!
大鼠Ⅱ型肺泡上皮细胞采用胰蛋白酶-胶原酶混合灌注消化法结合差...
刺糖多孢菌的培养条件与保存方法及注意事项!
刺糖多孢菌是Saccharopolyspora属的微生物,原...

炭疽杆菌的生物学性状与微生物学检查及实验室诊断!
炭疽杆菌属于需氧芽孢杆菌属,受低浓度青霉素作用,菌体可肿大形...

细胞培养中支原体污染的预防措施与处理方法!
支原体是目前已知一类能在无生命培养基上生长繁殖的最小的原核细...

大鼠内脏脂肪细胞提取物的背景与应用!
大鼠内脏脂肪细胞提取物是从大鼠原代内脏脂肪细胞提取的,大鼠原...
微生物检测过程中的常见问题及解答!
微生物检测过程中的常见问题及解答。
洋葱假单胞菌的生物学性状与细菌学检验方法!
洋葱假单胞菌存在于土壤及水中,因可使洋葱腐烂而得名。在医院环...